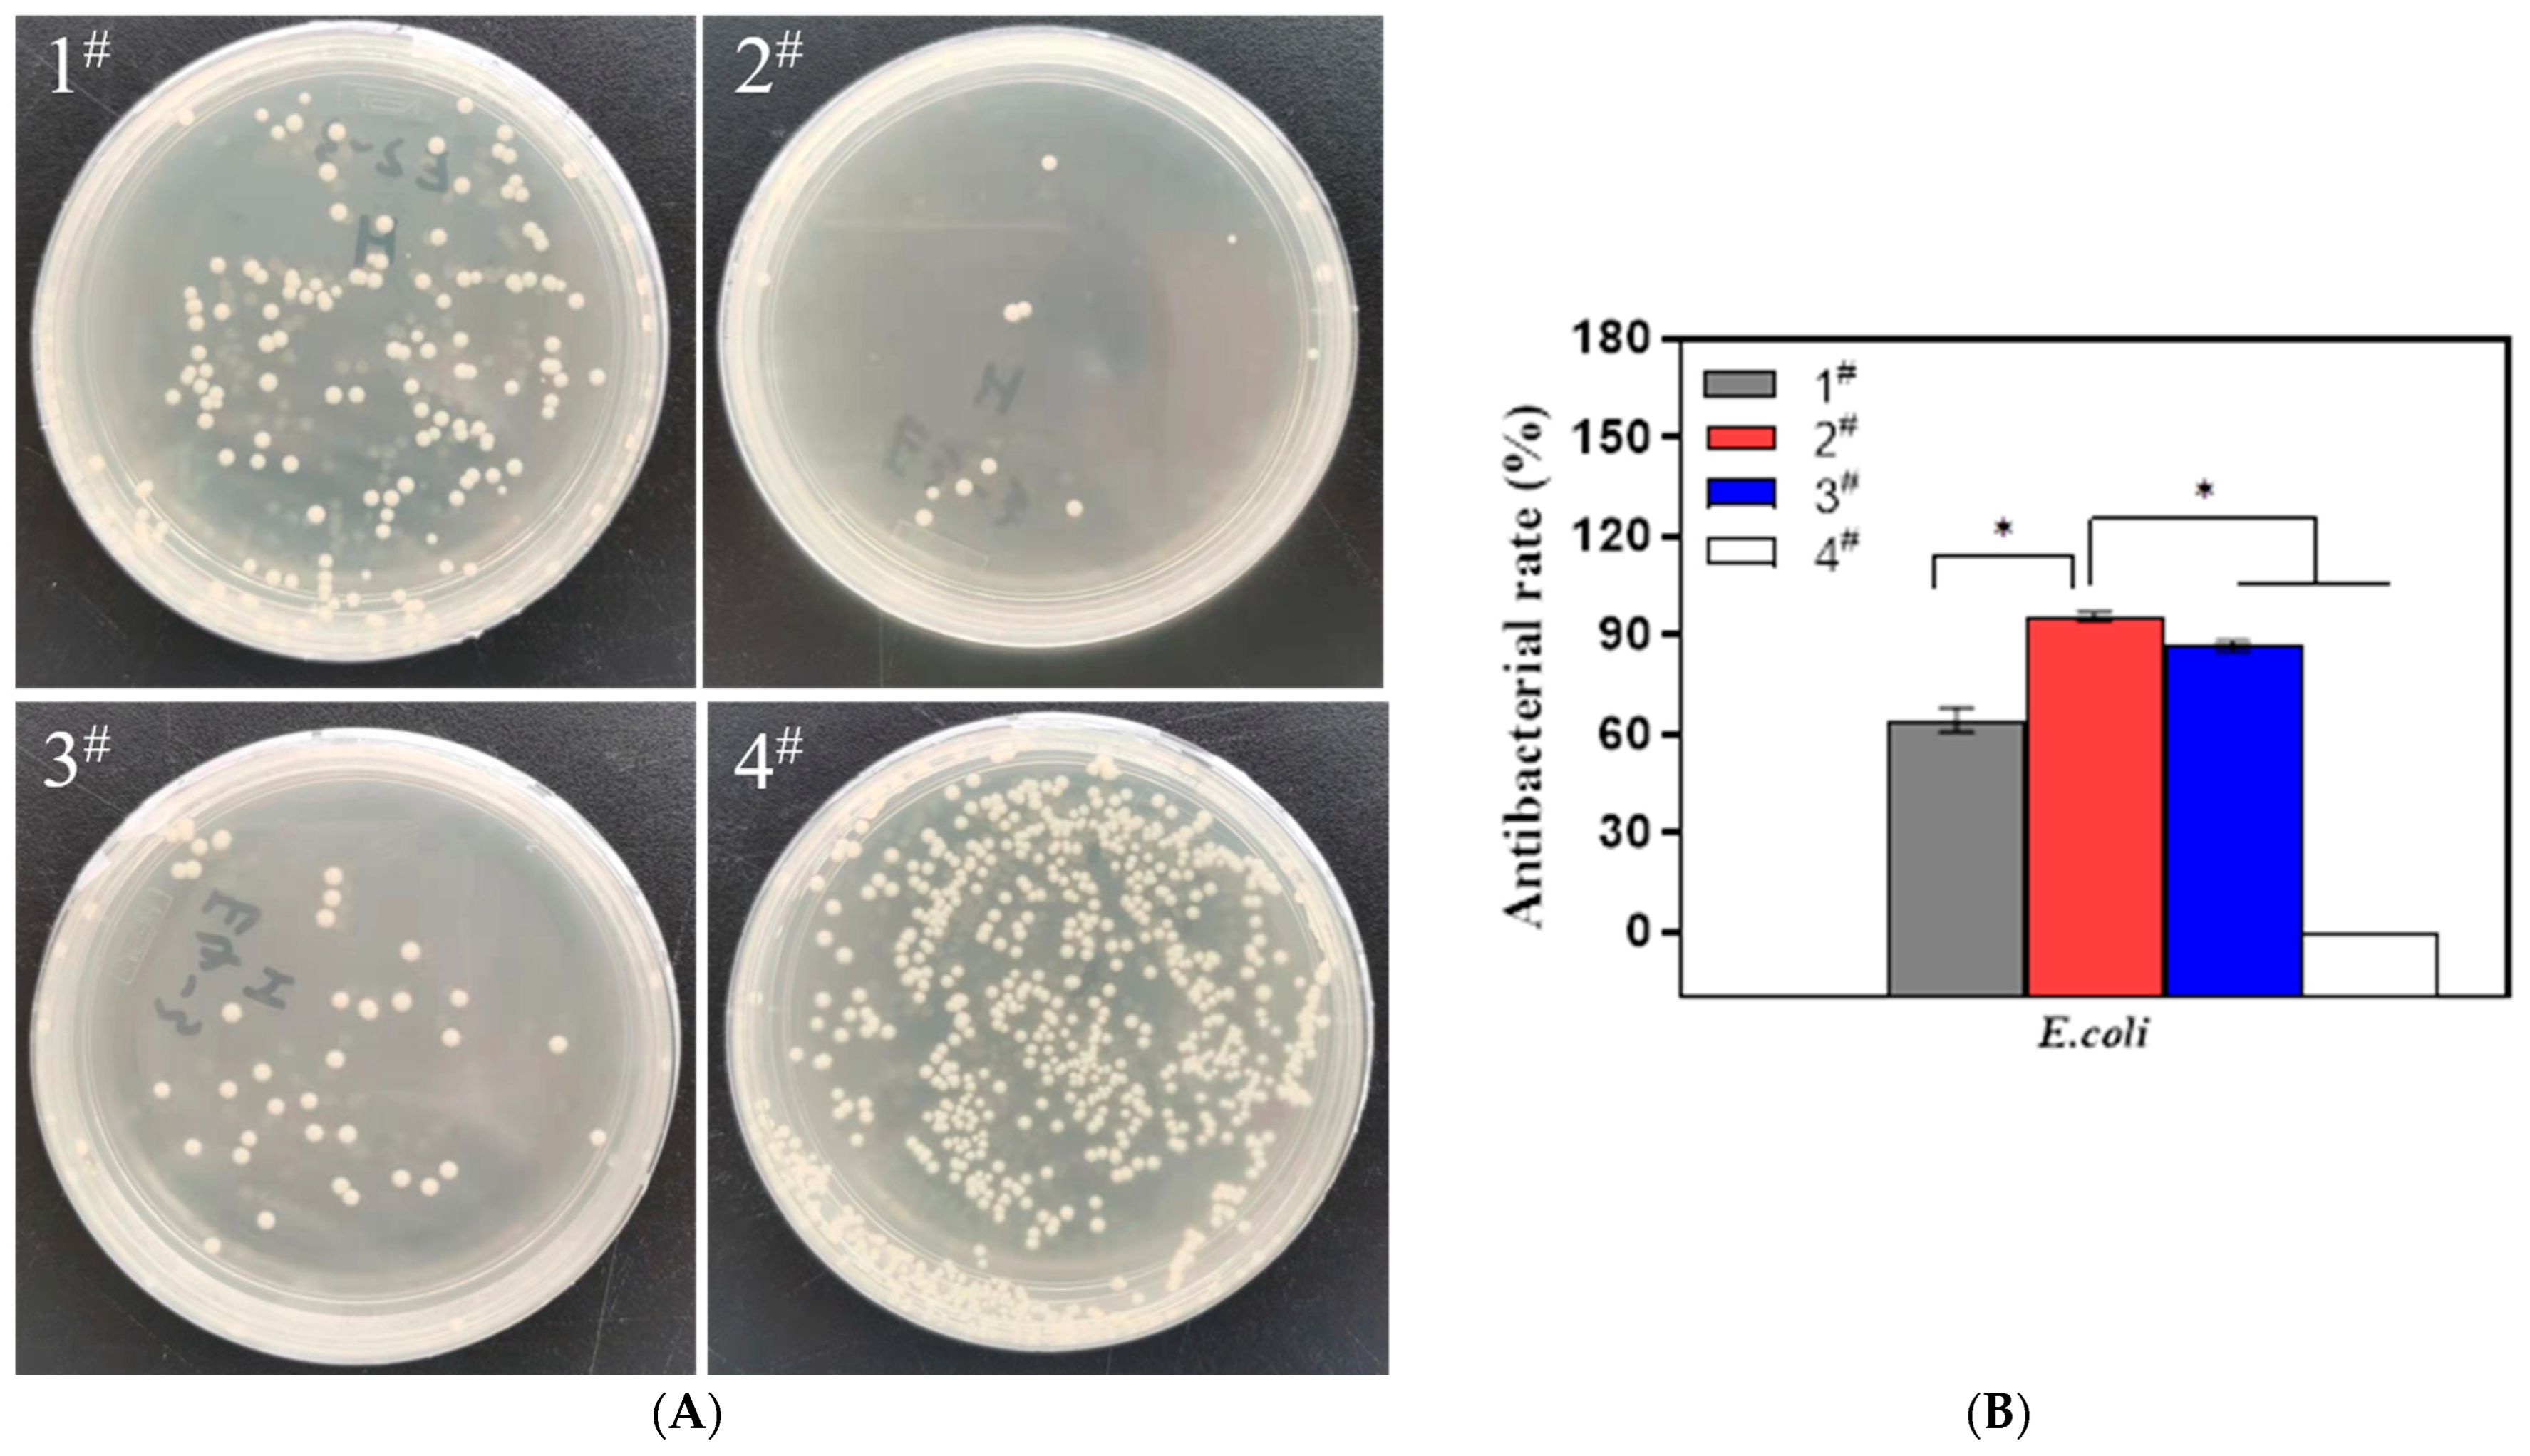
Metals 12 01391 g007 550

Synthesis, Characterization and Antimicrobial Studies of Ti-40Nb-10Ag Implant Biomaterials
Abstract
:1. Introduction
2. Materials and Methods
2.1. Preparation and Fabrication of Sample
2.2. Characterizations of Alloy
2.3. Antimicrobial Activity Tests
2.4. Statistical Analysis
3. Results
3.1. XRD
3.2. Microstructure
3.3. Microhardness
3.4. Mechanical Properties
3.5. Antibacterial Properties
4. Conclusions
- (1)
- Ti-40Nb-10Ag alloys were fabricated by spark plasma sintering technology with different sintering temperatures. The Ti-40Nb-10Ag alloys were composed mainly of α-Ti, β-Ti, and Ti2Ag intermetallic phases.
- (2)
- The change in sintering temperatures can affect the microstructure of the alloy, which results in changes in microhardness, compressive strength, and elastic modulus. When the sintering temperature was 975 °C, good metallurgical bonding was formed on the surface of the alloy with excellent microhardness, compressive strength, and elastic modulus.
- (3)
- The change in sintering temperature would affect the microstructure of the alloy, which results in the change in its antibacterial properties. When the sintering temperature was 975 °C, the alloy had excellent antibacterial ability and its antibacterial rate was 95.6%.
Author Contributions
Funding
Institutional Review Board Statement
Informed Consent Statement
Data Availability Statement
Conflicts of Interest
References
- Santos, R.F.M.; Ricci, V.P.; Afonso, C.R.M. Influence of Swaging on Microstructure, Elastic Modulus and Vickers Microhardness of beta Ti-40Nb Alloy for Implants. J. Mater. Eng. Perform. 2021, 30, 3363–3369. [Google Scholar] [CrossRef]
- Chen, Q.; Thouas, G.A. Metallic implant biomaterials. Mater. Sci. Eng. 2015, 87, 1–57. [Google Scholar] [CrossRef]
- Geetha, M.; Singh, A.K.; Asokamani, R.; Gogia, A.K. Ti based biomaterials, the ultimate choice for orthopaedic implants—A review. Prog. Mater. Sci. 2009, 54, 397–425. [Google Scholar] [CrossRef]
- de Andrade, D.P.; de Vasconcellos, L.M.R.; Carvalho, I.C.S.; Forte, L.; Santos, E.L.D.; do Prado, R.F.; dos Santos, D.R.; Cairo, C.A.A.; Carvalho, Y.R. Titanium-35niobium alloy as a potential material for biomedical implants: In vitro study. Mater. Sci. Eng. C 2015, 56, 538–544. [Google Scholar] [CrossRef] [PubMed]
- Reyes, K.M.; Kuromoto, N.K.; Claro, A.; Marino, C.E.B. Electrochemical stability of binary TiNb for biomedical applications. Mater. Res. Express 2017, 4, 075402. [Google Scholar] [CrossRef]
- Pilz, S.; Gebert, A.; Voss, A.; Oswald, S.; Gottlicher, M.; Hempel, U.; Eckert, J.; Rohnke, M.; Janek, J.; Calin, M. Metal release and cell biological compatibility of beta-type Ti-40Nb containing indium. J. Biomed. Mater. Res. Part B 2018, 106, 1686–1697. [Google Scholar] [CrossRef]
- Calin, M.; Helth, A.; Moreno, J.J.G.; Bonisch, M.; Brackmann, V.; Giebeler, L.; Gemming, T.; Lekka, C.E.; Gebert, A.; Schnettler, R.; et al. Elastic softening of beta-type Ti-Nb alloys by indium (In) additions. J. Mech. Behav. Biomed. Mater. 2014, 39, 162–174. [Google Scholar] [CrossRef]
- Niinomi, M.; Nakai, M. Titanium-Based Biomaterials for Preventing Stress Shielding between Implant Devices and Bone. Int. J. Biomater. 2011, 2011, 836587. [Google Scholar] [CrossRef] [Green Version]
- Fu, S.; Zhang, Y.; Qin, G.W.; Zhang, E.L. Antibacterial effect of Ti-Ag alloy motivated by Ag-containing phases. Mater. Sci. Eng. C 2021, 128, 112266. [Google Scholar] [CrossRef]
- Zhang, E.L.; Zhao, X.T.; Hu, J.L.; Wang, R.X.; Fu, S.; Qin, G.W. Antibacterial metals and alloys for potential biomedical implants. Bioact. Mater. 2021, 6, 2569–2612. [Google Scholar] [CrossRef]
- Casey, A.L.; Adams, D.; Karpanen, T.J.; Lambert, P.A.; Cookson, B.D.; Nightingale, P.; Miruszenko, L.; Shillam, R.; Christian, P.; Elliott, T.S. Role of copper in reducing hospital environment contamination. J. Hosp. Infect. 2010, 74, 72–77. [Google Scholar] [CrossRef] [PubMed]
- Xingeng, D.; Jianxiang, L.I.U.; Hui, Y. Microstructure of antibacterial film and the interface reaction to the stainless steel. Mater. Sci. Technol. 2006, 14, 370–372. [Google Scholar] [CrossRef]
- Liao, K.H.; Ou, K.L.; Cheng, H.C.; Lin, C.T.; Peng, P.W. Effect of silver on antibacterial properties of stainless steel. Appl. Surf. Sci. 2010, 256, 3642–3646. [Google Scholar] [CrossRef]
- Zhang, E.L.; Li, F.B.; Wang, H.Y.; Liu, J.; Wang, C.M.; Li, M.Q.; Yang, K. A new antibacterial titanium-copper sintered alloy: Preparation and antibacterial property. Mater. Sci. Eng. C 2013, 33, 4280–4287. [Google Scholar] [CrossRef]
- Bosetti, M.; Masse, A.; Tobin, E.; Cannas, M. Silver coated materials for external fixation devices: In vitro biocompatibility and genotoxicity. Biomaterials 2002, 23, 887–892. [Google Scholar] [CrossRef]
- Metalsmetalschen, M.A.; Zhang, E.L.; Zhang, L. Microstructure, mechanical properties, bio-corrosion properties and antibacterial properties of Ti-Ag sintered alloys. Mater. Sci. Eng. C 2016, 62, 350–360. [Google Scholar] [CrossRef]
- Uhthoff, H.K.; Finnegan, M. The effects of metal plates on post-traumatic remodelling and bone mass. J. Bone Jt. Surg. Br. Vol. 1983, 65, 66–71. [Google Scholar] [CrossRef] [Green Version]
- Long, M.; Rack, H.J. Titanium alloys in total joint replacement—A materials science perspective. Biomaterials 1998, 19, 1621–1639. [Google Scholar] [CrossRef]
- Fischer, M.; Laheurte, P.; Acquier, P.; Joguet, D.; Peltier, L.; Petithory, T.; Anselme, K.; Mille, P. Synthesis and characterization of Ti-27.5Nb alloy made by CLAD (R) additive manufacturing process for biomedical applications. Mater. Sci. Eng. C 2017, 75, 341–348. [Google Scholar] [CrossRef] [Green Version]
- Schmidt, R.; Pilz, S.; Lindemann, I.; Damm, C.; Hufenbach, J.; Helth, A.; Geissler, D.; Henss, A.; Rohnke, M.; Calin, M.; et al. Powder metallurgical processing of low modulus beta-type Ti-45Nb to bulk and macro-porous compacts. Powder Technol. 2017, 322, 393–401. [Google Scholar] [CrossRef]
- Sun, P.; Fang, Z.G.Z.; Zhang, Y.; Xia, Y. Review of the Methods for Production of Spherical Ti and Ti Alloy Powder. JOM 2017, 69, 1853–1860. [Google Scholar] [CrossRef] [Green Version]
- Liu, M.; Wang, Z.G.; Shi, C.B.; Wang, L.W.; Xue, X.D. Corrosion and wear behavior of Ti-30Zr alloy for dental implants. Mater. Res. Express 2019, 6, 0865c8. [Google Scholar] [CrossRef]
- Annur, D.; Kartika, I.; Supriadi, S.; Suharno, B. Titanium and titanium based alloy prepared by spark plasma sintering method for biomedical implant applications-a review. Mater. Res. Express 2021, 8, 012001. [Google Scholar] [CrossRef]
- Chavez, J.; Olmos, L.; Jimenez, O.; Alvarado-Hernandez, F.; Flores-Zuniga, H.; Camarillo-Garcia, J.P.; Guevara-Martinez, S.J. Investigation of a Ti-30Zr binary alloy fabricated through spark plasma sintering. J. Mater. Res. Technol. 2020, 9, 9328–9340. [Google Scholar] [CrossRef]
- Karre, R.; Kodli, B.K.; Rajendran, A.; Nivedhitha, J.; Pattanayak, D.K.; Ameyama, K.; Dey, S.R. Comparative study on Ti-Nb binary alloys fabricated through spark plasma sintering and conventional P/M routes for biomedical application. Mater. Sci. Eng. C 2019, 94, 619–627. [Google Scholar] [CrossRef]
- Li, H.F.; Qiu, K.J.; Yuan, W.; Zhou, F.Y.; Wang, B.L.; Li, L.; Zheng, Y.F.; Liu, Y.H. Screening on binary Ti alloy with excellent mechanical property and castability for dental prosthesis application. Sci. Rep. 2016, 6, 37428. [Google Scholar] [CrossRef]
- Zhang, Y.Q.; Sun, D.N.; Cheng, J.; Tsoi, J.K.H.; Chen, J. Mechanical and biological properties of Ti-(0–25 wt%)Nb alloys for biomedical implants application. Regener. Biomater. 2020, 7, 119–128. [Google Scholar] [CrossRef] [Green Version]
- Kim, T.I.; Han, J.H.; Lee, I.S.; Lee, K.H.; Shin, M.C.; Choi, B.B. New titanium alloys for biomaterials: A study of mechanical and corrosion properties and cytotoxicity. Bio-Med. Mater. Eng. 1997, 7, 253–263. [Google Scholar] [CrossRef]
- Elmay, W.; Patoor, E.; Bolle, B.; Gloriant, T.; Prima, F.; Eberhardt, A.; Laheurte, P. Optimisation of mechanical properties of Ti-Nb binary alloys for biomedical applications. Comput. Methods Biomech. Biomed. Eng. 2011, 14, 119–120. [Google Scholar] [CrossRef]
- Ou, K.L.; Weng, C.C.; Lin, Y.H.; Huang, M.S. A promising of alloying modified beta-type Titanium-Niobium implant for biomedical applications: Microstructural characteristics, in vitro biocompatibility and antibacterial performance. J. Alloys Compd. 2017, 697, 231–238. [Google Scholar] [CrossRef]
- Chen, L.Y.; Cui, Y.W.; Zhang, L.C. Recent Development in Beta Titanium Alloys for Biomedical Applications. Metals 2020, 10, 1139. [Google Scholar] [CrossRef]
- Wen, M.; Wen, C.; Hodgson, P.; Li, Y.C. Fabrication of Ti-Nb-Ag alloy via powder metallurgy for biomedical applications. Mater. Des. 2014, 56, 629–634. [Google Scholar] [CrossRef]
- Kang, M.K.; Moon, S.K.; Kwon, J.S.; Kim, K.M.; Kim, K.N. Antibacterial effect of sand blasted, large-grit, acid-etched treated Ti-Ag alloys. Mater. Res. Bull. 2012, 47, 2952–2955. [Google Scholar] [CrossRef]
- Maharubin, S.; Hu, Y.B.; Sooriyaarachchi, D.; Cong, W.L.; Tan, G.Z. Laser engineered net shaping of antimicrobial and biocompatible titanium-silver alloys. Mater. Sci. Eng. C 2019, 105, 110059. [Google Scholar] [CrossRef]
- Bruna, T.; Maldonado-Bravo, F.; Jara, P.; Caro, N. Silver Nanoparticles and Their Antibacterial Applications. Int. J. Mol. Sci. 2021, 22, 7202. [Google Scholar] [CrossRef] [PubMed]
- Duran, N.; Duran, M.; de Jesus, M.B.; Seabra, A.B.; Favaro, W.J.; Nakazato, G. Silver nanoparticles: A new view on mechanistic aspects on antimicrobial activity. Nanomedicine 2016, 12, 789–799. [Google Scholar] [CrossRef]
- Xu, Z.; Zhang, C.; Wang, X.; Liu, D. Release Strategies of Silver Ions from Materials for Bacterial Killing. ACS Appl. Bio. Mater. 2021, 4, 3985–3999. [Google Scholar] [CrossRef]
- Guo, T.; Ma, Y.L.; Guo, P.; Xu, Z.R. Antibacterial effects of the Cu(II)-exchanged montmorillonite on Escherichia coli K88 and Salmonella choleraesuis. Vet. Microbiol. 2005, 105, 113–122. [Google Scholar] [CrossRef]
- Zhang, Z.X.; Lin, G.; Jiang, L.Z.; Xu, Z. Beneficial effects of nitrogen on austenite antibacterial stainless steels. Mater. Chem. Phys. 2008, 111, 238–243. [Google Scholar] [CrossRef]
- Salleh, A.; Naomi, R.; Utami, N.D.; Mohammad, A.W.; Mahmoudi, E.; Mustafa, N.; Fauzi, M.B. The Potential of Silver Nanoparticles for Antiviral and Antibacterial Applications: A Mechanism of Action. Nanomaterials 2020, 10, 1566. [Google Scholar] [CrossRef]
- Qing, Y.; Cheng, L.; Li, R.; Liu, G.; Zhang, Y.; Tang, X.; Wang, J.; Liu, H.; Qin, Y. Potential antibacterial mechanism of silver nanoparticles and the optimization of orthopedic implants by advanced modification technologies. Int. J. Nanomed. 2018, 13, 3311–3327. [Google Scholar] [CrossRef] [PubMed] [Green Version]

| Sample | Alloy | Temperature (°C) |
|---|---|---|
| 1# | Ti-40Nb-10Ag | 950 |
| 2# | Ti-40Nb-10Ag | 975 |
| 3# | Ti-40Nb-10Ag | 1000 |
| 4# | Ti-40Nb | 975 |
Publisher’s Note: MDPI stays neutral with regard to jurisdictional claims in published maps and institutional affiliations. |
© 2022 by the authors. Licensee MDPI, Basel, Switzerland. This article is an open access article distributed under the terms and conditions of the Creative Commons Attribution (CC BY) license (https://creativecommons.org/licenses/by/4.0/).
Share and Cite
Zhu, B.; Zhang, Y.; Chen, Y.; Yuan, P.; Wang, W.; Duan, H.; Wang, Z. Synthesis, Characterization and Antimicrobial Studies of Ti-40Nb-10Ag Implant Biomaterials. Metals 2022, 12, 1391. https://doi.org/10.3390/met12081391
Zhu B, Zhang Y, Chen Y, Yuan P, Wang W, Duan H, Wang Z. Synthesis, Characterization and Antimicrobial Studies of Ti-40Nb-10Ag Implant Biomaterials. Metals. 2022; 12(8):1391. https://doi.org/10.3390/met12081391
Chicago/Turabian StyleZhu, Bin, Yuqin Zhang, Yongcheng Chen, Ping Yuan, Wentong Wang, Hao Duan, and Zhihua Wang. 2022. "Synthesis, Characterization and Antimicrobial Studies of Ti-40Nb-10Ag Implant Biomaterials" Metals 12, no. 8: 1391. https://doi.org/10.3390/met12081391
APA StyleZhu, B., Zhang, Y., Chen, Y., Yuan, P., Wang, W., Duan, H., & Wang, Z. (2022). Synthesis, Characterization and Antimicrobial Studies of Ti-40Nb-10Ag Implant Biomaterials. Metals, 12(8), 1391. https://doi.org/10.3390/met12081391
